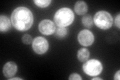
YCR024C-A

View description
Small single-membrane span proteolipid that functions as a regulatory subunit of the plasma membrane H(+)-ATPase Pma1p, forms unique helix and positively charged cytoplasmic domain that is able to specifically segregate phosphatidylserines
Localization:
Intensity:
Fold change:
Significance:
-
C’ GFP library in SD

vacuole:cell periphery392.92 -
N' NOP1pr-GFP in SD

N/A0 -
N' TEF2pr-mCherry in SD

N/A0 -
N' NATIVEpr-GFP in SD

N/A0 -
N' TEF2pr-VC and Cyto-VN in SD

N/A0 -
C’ GFP library in SD+DTT

vacuole.cell periphery340.170.86No -
C’ GFP library in SD+H2O2

vacuole.cell periphery451.361.14No -
C’ GFP library in Starvation Media
vacuole,cell periphery469.551.19No -
C’ GFP library on the background of Pup2-DaMP

vacuole:cell periphery -
C’ GFP library on the background of CCT mutant

vacuole:cell periphery394.8091.00478No
